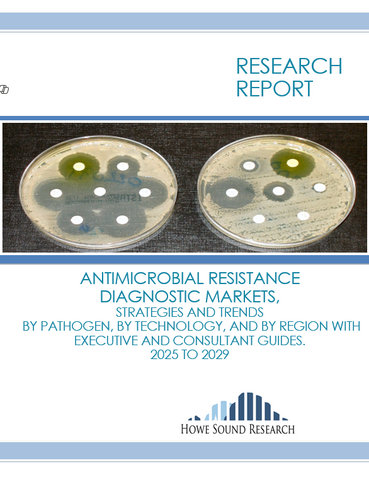
ANTIMICROBIAL RESISTANCE DIAGNOSTIC MARKETS

Latent Tuberculosis Diagnostic Markets
$3,500.00
SEE the Table of Contents.
GET the Free Sample of this Report.
Many organizations subscribe to all or some of our reports. You may already have free access to this report. FIND out Here.
" LATENT TB DIAGNOSTICS Global Markets by Assay, by Risk Factor, and by Lab/Place. With Executive and Consultant Guides and Market Analysis and Forecasts 2025 - 2029"
322 Pages packed with information.
New opportunity in a once mature market now on a growth track….
Latent TB Diagnostics was the province of a few established companies producing a commodity product. No longer. New technologies. New niche markets.
TB Diagnostics is growing, and in some segments the growth is dramatic. Find out who the new leaders are and what areas are most lucrative. What are the basics of competition?
The report forecasts the market size out five years. Some players have already made their mark but disruptive diagnostic technology could change the playing field. Learn about this market including the issues and outlooks.
Our research makes you the expert in your organization. Get our research team working for you by ordering all, or a portion, of this comprehensive report. Your credit card order sends the report to your inbox instantly. Check all your licensing options but don't worry, your order is available as a credit if you wish to upgrade to more information. We wrote this report and we are ready, by phone or email, to help you use it. As always, assistance, and additional specific data, is provided without additional charges.
All report data is available in Excel format on request.
SEE the Table of Contents.
GET the Free Sample of this Report.
Many organizations subscribe to all or some of our reports. You may already have free access to this report. FIND out Here.
ABOUT THE LEAD AUTHOR

Mr. Greg Powell, B.SC., M.B.A is the President of Howe Sound Research. His education includes:
Finance for Senior Executives - Harvard Business School
Market Research - Burke Institute
M.B.A. (Finance and Policy) - University of British Columbia
B.Sc. (Chemistry) - University of British Columbia
He is an experienced business and clinical professional. He is co-author of the paper "The Radioimmunoassay of Angiotensinogen by Antibody Trapping." He has worked in laboratory testing and management for over 20 years.

Share this item: